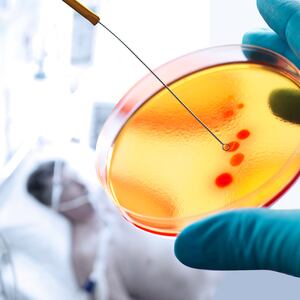

The antibiotic-resistant bacterium known as MRSA is common in health-care settings, but an outbreak at a Pittsburgh hospital is causing concern because it was found in the neonatal intensive care unit—full of newborn babies whose immune systems aren’t fully developed.
Hard-to-treat methicillin-resistant Staphylococcus aureus was confirmed in six babies and six adults at the University of Pittsburgh Medical Center Children's Hospital NICU, the hospital confirmed this week. The patients were put into isolation, in accordance with guidelines from the Centers for Disease Control.
The state health department referred calls to the Alleghany County health department, which refused to answer any questions. A spokesman requested that all questions be directed to UPMC, where officials declined to elaborate or answer follow-up questions about the situation.
The statement said that of the six infants who tested positive, only one has symptoms of infection. Several staff members have possible symptoms, the hospital said.
Rodney Rohde, chair of the Clinical Laboratory Science program at Texas State University and a top expert on MRSA, said the germ has been a growing public health problem since it was discovered in the '40s.
“It’s a bacterium that becomes resistant to whole families of drugs,” he told The Daily Beast, adding that a MRSA outbreak can be caused by an overuse of antibiotics.
MRSA can cause staph infections which can lead to pneumonia, blood infections, and if left untreated, even deadly sepsis.
“A MRSA outbreak is especially concerning in an NICU, where you have an entire population of immuno-compromised people, like infants, whose immune systems haven’t fully developed,” he said.
About 1 to 2 percent of the population are carriers for MRSA without developing symptoms, Rohde said. Because it’s so prevalent, some hospitals have contemplated running cultures on potential carriers who could distribute it to people too sick to fight off an infection.
Any staph infection can be dangerous, In 2017, nearly 20,000 people died after the bacteria got into their bloodstream, according to the CDC.
Dr. Amesh Adalja, a senior scholar at the Johns Hopkins University Center for Health Security, noted that hospitals are accustomed to dealing with MRSA. “And we’re seeing proactive, aggressive approach with the press releases and early collaboration with the Department of Health,” Adalja said of UPMC’s response.
After an MRSA outbreak, affected patients are isolated and medical staff wear protective gear until it’s safe. Usually the isolation will last for as long as the patient is in the hospital.